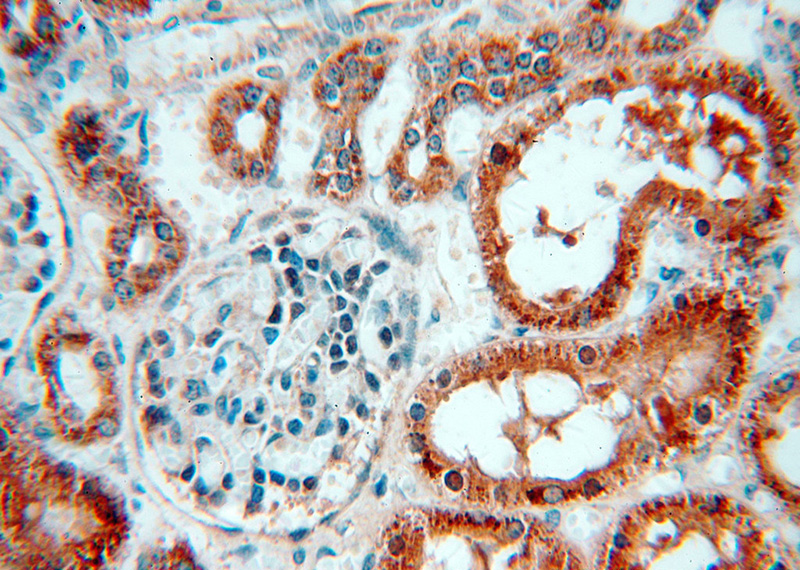
Immunohistochemical of paraffin-embedded human kidney using Catalog No:108876(CASP3 antibody) at dilution of 1:50 (under 40x lens)

-
Product Name
Caspase 3/p17 antibody
- Documents
-
Description
Caspase 3/p17 Rabbit Polyclonal antibody. Positive WB detected in Jurkat cells, HeLa cells, mouse spleen tissue. Positive IP detected in NIH/3T3 cells. Positive IF detected in NIH/3T3 cells. Positive IHC detected in human kidney tissue, human spleen tissue. Observed molecular weight by Western-blot: 32-35 kDa
-
Tested applications
ELISA, IHC, WB, IF, IP
-
Species reactivity
Human,Mouse,Rat; other species not tested.
-
Alternative names
Apopain antibody; CASP 3 antibody; CASP3 antibody; Caspase 3 antibody; Caspase 3/p17 antibody; Caspase3 antibody; CPP 32 antibody; CPP32 antibody; CPP32B antibody; Cysteine protease CPP32 antibody; Protein Yama antibody; SCA 1 antibody; SREBP cleavage activity 1 antibody
-
Isotype
Rabbit IgG
-
Preparation
This antibody was obtained by immunization of Peptide (Accession Number: NM_004346). Purification method: Antigen affinity purified.
-
Clonality
Polyclonal
-
Formulation
PBS with 0.02% sodium azide and 50% glycerol pH 7.3.
-
Storage instructions
Store at -20℃. DO NOT ALIQUOT
-
Applications
Recommended Dilution:
WB: 1:200-1:2000
IP: 1:200-1:2000
IHC: 1:20-1:200
IF: 1:20-1:200
-
Validations

Jurkat cells were subjected to SDS PAGE followed by western blot with Catalog No:108876(Caspase 3 Antibody) at dilution of 1:600

Immunohistochemical of paraffin-embedded human kidney using Catalog No:108876(CASP3 antibody) at dilution of 1:50 (under 10x lens)
Immunohistochemical of paraffin-embedded human kidney using Catalog No:108876(CASP3 antibody) at dilution of 1:50 (under 40x lens)

IP Result of anti-Caspase 3 (IP:Catalog No:108876, 4ug; Detection:Catalog No:108876 1:500) with NIH/3T3 cells lysate 2000ug.

Immunofluorescent analysis of (-20oc Ethanol) fixed NIH/3T3 cells using Catalog No:108876(Caspase 3 Antibody) at dilution of 1:50 and Alexa Fluor 488-congugated AffiniPure Goat Anti-Rabbit IgG(H+L)
-
Background
Caspase 3, also named as CPP32, SCA-1 and Apopain, belongs to the peptidase C14A family. Caspase 3 is involved in the activation cascade of caspases responsible for apoptosis execution. At the onset of apoptosis it proteolytically cleaves poly(ADP-ribose) polymerase (PARP) at a '216-Asp-|-Gly-217' bond. Caspase 3 cleaves and activates sterol regulatory element binding proteins (SREBPs) between the basic helix-loop-helix leucine zipper domain and the membrane attachment domain. Cleaves and activates caspase-6, -7 and -9. Caspase 3 is involved in the cleavage of huntingtin. The antibody can recognize p17 and p32 of Caspase 3.
-
References
- Xia X, Su C, Fu J. Role of α-lipoic acid in LPS/d-GalN induced fulminant hepatic failure in mice: studies on oxidative stress, inflammation and apoptosis. International immunopharmacology. 22(2):293-302. 2014.
- Xu D, Hu L, Su C. Tetrachloro-p-benzoquinone induces hepatic oxidative damage and inflammatory response, but not apoptosis in mouse: the prevention of curcumin. Toxicology and applied pharmacology. 280(2):305-13. 2014.
- Li M, Lu Y, Hu Y. Salvianolic acid B protects against acute ethanol-induced liver injury through SIRT1-mediated deacetylation of p53 in rats. Toxicology letters. 228(2):67-74. 2014.
- An J, Zhang X, Qin J. The histone methyltransferase ESET is required for the survival of spermatogonial stem/progenitor cells in mice. Cell death & disease. 5:e1196. 2014.
- Liang Z, Yi Y, Guo Y, Wang R, Hu Q, Xiong X. Chemical characterization and antitumor activities of polysaccharide extracted from Ganoderma lucidum. International journal of molecular sciences. 15(5):9103-16. 2014.
- Xie M, Yi X, Wang R. 14-Thienyl methylene matrine (YYJ18), the derivative from matrine, induces apoptosis of human nasopharyngeal carcinoma cells by targeting MAPK and PI3K/Akt pathways in vitro. Cellular physiology and biochemistry : international journal of experimental cellular physiology, biochemistry, and pharmacology. 33(5):1475-83. 2014.
- Wang CP, Li GC, Shi YW. Neuroprotective effect of schizandrin A on oxygen and glucose deprivation/reperfusion-induced cell injury in primary culture of rat cortical neurons. Journal of physiology and biochemistry. 70(3):735-47. 2014.
- Liang Z, Guo YT, Yi YJ, Wang RC, Hu QL, Xiong XY. Ganoderma lucidum polysaccharides target a Fas/caspase dependent pathway to induce apoptosis in human colon cancer cells. Asian Pacific journal of cancer prevention : APJCP. 15(9):3981-6. 2014.
Related Products / Services
Please note: All products are "FOR RESEARCH USE ONLY AND ARE NOT INTENDED FOR DIAGNOSTIC OR THERAPEUTIC USE"
